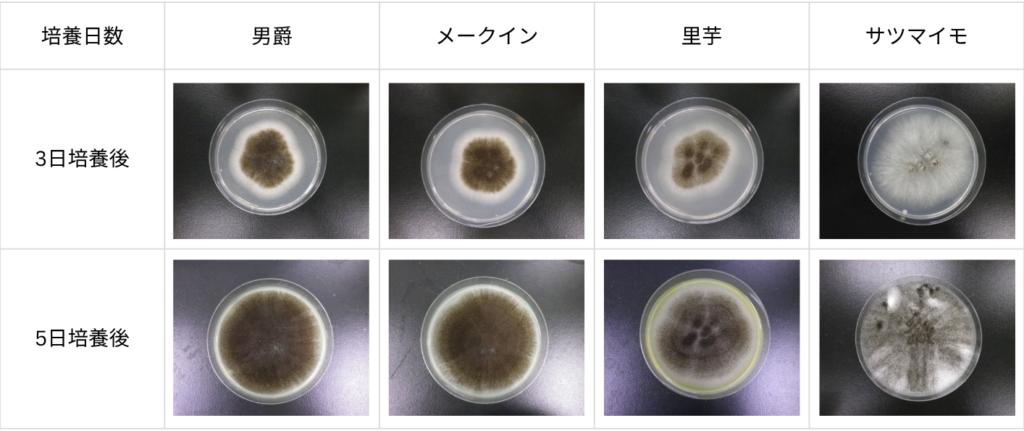

2024/12/02
《化学物質のいろは》第14弾 ビスフェノール類
おさえておきたい基礎知識
2026/04/20

皆さんは、キッチンの隅でうっかり芽が出てしまったジャガイモを見つけたことはありませんか?「早く料理に使わなきゃ」と焦る日常の風景ですが、私たち試験担当者にとってジャガイモは、とても身近な「微生物のごはん(培地)」の材料でもあります。
前回のコラム(独白16)では、微生物を育てるための「培地」についてお話しました。その中でも、かびを生育する際によく使われるのが「ポテトデキストロース寒天培地」(PDA培地)です。PDA培地は、その名の通り、ジャガイモ、糖分、寒天からできています。そこで疑問に思ったのが、
「ジャガイモじゃなく、里芋でもかびは育つのかな?」

普段の試験では粉末培地を使用しており、生のイモから作ることはありません。
そこで今回は、培地を実際に手作りしてみました!
今回は男爵(ジャガイモ)、メークイン(ジャガイモ)、里芋、サツマイモの4種類のイモで培地を作ってみました。
(余談ですが、サトイモは“Taro”なのでTDA、サツマイモは“Sweet Potato”なのでSPDAと呼べそうですね。)

作成中は甘い匂いがあたり一面に漂い、完成した寒天培地からも甘いおいしそうな匂いがしました。
また、完成した培地を並べてみると、イモの種類によって色味にわずかな違いが見られました。

これで準備万端!
それでは、かびの育成チャレンジへ!!
完成した4種類の培地に、実際にかびを接種し、かびが生育するのか確認してみました。
すべての培地でかびが生育しましたが、胞子の形成量が大きく異なりました。
ジャガイモの男爵とメークイン間であまり差は見られませんでしたが、里芋はジャガイモに比べると胞子の形成量が少なかったです。またサツマイモは、胞子の形成量が他に比べて圧倒的に少ないという結果になりました。これは、それぞれのイモに含まれる糖分の量や、ビタミン類などの違いが生育に影響している可能性があります。
また今回はジャガイモを前提とした配合で作製しているため、里芋やサツマイモで十分な胞子形成を得るには、ブドウ糖の量や里芋やサツマイモ自体の量を変えたりする必要があるかもしれませんね。
実際に培地を一から作ってみると、皮むき、カット、煮る、ろ過と工程が多く、想像以上に手間がかかりました。普段使用している粉末培地は、水に溶かすだけで調製できるため、その便利さを改めて実感しました。
ちなみに培地にはその名の通り、オートミールが入っている「オートミール培地」や、ジャガイモとニンジンの入った「ポテトキャロットアガー」なんてものもあります。遊びで、身近にある様々な食材で培地を作ってみるのも面白そうですね。もしかしたら、想像を絶するほどのかびが生えてくるかもしれません。
バイオケミカルグループでは、さまざまな製品の抗菌・抗ウイルス試験や、消臭・防臭試験などを行っています。「該当する試験規格がなく、評価の進め方が分からない」「どう評価すればいいか分からない」など、評価方法のご相談から対応しておりますので、お気軽にお問い合わせください。
【コラム執筆担当】
一般財団法人ニッセンケン品質評価センター
ライフ アンド ヘルス事業本部 バイオケミカルグループ
本コラム「試験担当者のひとり言」は、毎月2回(5日・20日)更新しています。
次回もお楽しみに!
■関連記事
お役立ちな独白16 培地ってなに?-微生物を育てるごはんの話-
お役立ちな独白8 抗かび効果を出すには?薬用シャンプー評価で見えた“条件設定”の盲点
お役立ちな独白13 “嫌われ者”防腐剤の重要性を再確認 -手作り化粧水の防腐力を検証-
おさえておきたい基礎知識
各種お問い合わせCONTACT
サービス全般についてのお問い合わせ
![]()
各種試験・検査に関するお問い合わせ、ご依頼はこちらから承ります。
エコテックス®に対するお問い合わせ
![]()
エコテックス®認証に関するお問い合わせ、ご依頼はこちらから承ります。
技術資料ダウンロード
![]()
各種試験・検査に関する技術資料が、こちらからダウンロードいただけます。
よくあるご質問
![]()
試験・検査などで、皆さまからよくいただく質問と回答をまとめています。
お電話からのお問い合わせはこちら